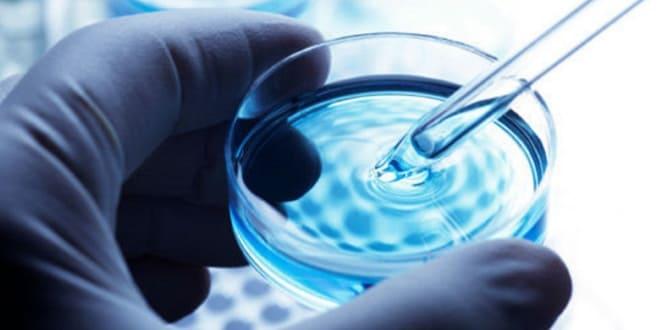
ЭКО при неработающих придатках

Синдром истощённых яичников (СИЯ) — серьёзное нарушение, влияющее на репродуктивное здоровье женщины, снижая фертильность и приводя к преждевременному прекращению менструаций. В статье рассмотрим возможность беременности при этом состоянии и современные методы, помогающие женщинам с СИЯ зачать и выносить здорового ребёнка. Понимание механизмов истощения яичников и доступных вариантов лечения важно для женщин, стремящихся к материнству, и может повысить шансы на успешную беременность.
Почему происходит истощение яичников
Патология развивается вследствие длительных заболеваний репродуктивной системы, нарушений в работе эндокринных желез и под воздействием ряда других факторов. К основным причинам истощения придатков можно отнести:
- аутоиммунные расстройства;
- гормональные нарушения;
- воспалительные или инфекционные процессы в половых органах;
- перенесенные курсы лучевой или химиотерапии;
- тяжелые формы малярии, оспы и других заболеваний;
- раннее начало менструаций;
- неблагоприятные экологические условия;
- вредные условия труда;
- бесконтрольный прием гормональных препаратов.
Также существует временная дисфункция яичников, которая может возникнуть до окончания лактации, после родов или при использовании оральных контрацептивов. В таких случаях восстановление функции органов происходит в течение нескольких месяцев. Если менструальный цикл не восстанавливается, рекомендуется пройти диагностику.
Эксперты в области репродуктивной медицины отмечают, что синдром истощённых яичников (СИЯ) представляет собой серьёзное состояние, при котором яичники теряют свою функцию до 40 лет. Несмотря на это, вероятность наступления беременности у женщин с СИЯ не исключена. В некоторых случаях возможно спонтанное зачатие, особенно если у пациентки сохраняются менструации и фолликулы. Однако, как правило, для достижения беременности требуется помощь репродуктивных технологий, таких как экстракорпоральное оплодотворение (ЭКО). Важно, чтобы женщины с данным синдромом проходили регулярные обследования и консультировались с врачами, чтобы оценить свои шансы на успешное зачатие и выбрать оптимальную стратегию лечения.

Возможно ли зачатие при синдроме истощенных яичников
Это заболевание проявляется уменьшением размеров яичников и снижением их функциональной активности до минимальных уровней. Основные признаки включают:
- замедленный рост фолликулов или полное отсутствие их развития;
- пониженный уровень половых гормонов из-за снижения эндокринной функции яичников;
- отсутствие овуляции;
- невозможность забеременеть.
Состояние сопровождается нарушениями менструального цикла, аменореей и скудными менструациями. Также могут наблюдаться симптомы гормонального дисбаланса, такие как перепады настроения, ухудшение состояния кожи, волос и ногтей, приливы жара и нестабильное артериальное давление.
Вероятность беременности при синдроме истощенных яичников крайне низка. Это связано с отсутствием созревания яйцеклетки и ее выходом для оплодотворения. Шансы на зачатие увеличиваются при наличии овуляции, которая может происходить хотя бы в одном из циклов. Однако вероятность забеременеть остается низкой из-за недостаточности второй фазы менструального цикла, вызванной истощением яичников. Желтое тело в этом случае не способно вырабатывать достаточное количество прогестерона, необходимого для успешной имплантации эмбриона в эндометрий матки.
Беременность может произойти при временном восстановлении функции яичников. Это состояние, возникающее на фоне истощенных яичников, называется ремиссией и может длиться от нескольких месяцев до нескольких лет. Однако оно не наблюдается у всех женщин и не всегда, поэтому ожидание его наступления без соответствующего лечения может привести к риску преждевременного климакса.
| Фактор | Влияние на вероятность наступления беременности при СИЯ | Комментарий |
|---|---|---|
| Возраст женщины | Значительно снижает вероятность | Чем старше женщина, тем меньше остается фолликулов в яичниках, снижается качество яйцеклеток. |
| Уровень АМГ (анти-мюллеров гормон) | Низкий уровень указывает на сниженный овариальный резерв, снижая вероятность | Низкий АМГ – один из основных маркеров СИЯ. |
| Количество антральных фолликулов | Низкое количество свидетельствует о малом количестве яйцеклеток | Оценивается при УЗИ. |
| Результаты стимуляции яичников | Слабый или отсутствующий ответ на стимуляцию указывает на низкий овариальный резерв | Проводится для оценки реакции яичников на гормональную терапию. |
| Наличие собственных жизнеспособных яйцеклеток | Необходимое условие для естественного зачатия | Может быть подтверждено анализами и процедурами ЭКО. |
| Методы вспомогательных репродуктивных технологий (ВРТ) | Повышают вероятность, но не гарантируют успех | ЭКО с донорскими яйцеклетками – наиболее эффективный метод. |
| Общее состояние здоровья | Влияет на успешность зачатия и вынашивания | Наличие сопутствующих заболеваний может осложнить беременность. |
Интересные факты
Синдром истощённых яичников (СИЯ) — это состояние, при котором яичники прекращают функционировать до 40 лет, что может привести к бесплодию. Однако, несмотря на это, существуют некоторые интересные факты о возможности наступления беременности при этом синдроме:
-
Спонтанная беременность: Хотя вероятность спонтанной беременности при синдроме истощённых яичников значительно снижена, некоторые женщины всё же могут забеременеть естественным образом. Это может произойти, если у них сохраняется хотя бы небольшое количество функциональных фолликулов.
-
Использование донорских яйцеклеток: Женщины с СИЯ могут рассмотреть возможность использования донорских яйцеклеток для достижения беременности. Это позволяет обойти проблему недостатка собственных яйцеклеток и значительно увеличивает шансы на успешную беременность.
-
Гормональная терапия: В некоторых случаях гормональная терапия может помочь восстановить менструальный цикл и улучшить шансы на зачатие. Это может включать использование эстрогенов и прогестерона, что иногда приводит к возможности беременности даже при наличии синдрома истощённых яичников.
Эти факты подчеркивают, что, несмотря на сложности, связанные с СИЯ, существуют варианты и возможности для женщин, желающих стать матерями.
Способы зачатия
При наличии синдрома истощенных яичников женщине следует рассмотреть все возможные способы, которые могут повысить вероятность зачатия. Это может включать как медикаментозное, так и хирургическое вмешательство, а также методы искусственного оплодотворения. В исключительных ситуациях эмбрион может самостоятельно прикрепиться к стенке матки без необходимости в каком-либо лечении.
Естественный способ
Вероятность зачатия возрастает при регулярной интимной жизни. Наличие сперматозоидов в матке играет важную роль, особенно при нерегулярной овуляции, когда трудно предсказать момент её наступления. В таких случаях определить беременность может быть сложно из-за частых задержек менструации. Поэтому женщинам рекомендуется проводить домашние тесты на беременность каждые 1-2 недели для своевременного выявления возможного зачатия.
Рекомендуется заниматься сексом 2-4 раза в неделю. Это обеспечит постоянное присутствие сперматозоидов в матке, готовых к оплодотворению. Оптимальным вариантом считается интимная близость каждые два дня. При более частых половых контактах сперматозоиды могут быть недостаточно зрелыми и сильными для успешного проникновения в яйцеклетку.
После проведенного лечения
Для лечения истощенных яичников с целью последующего планирования беременности назначаются гормональные препараты. В дополнение могут быть использованы противовоспалительные, антибактериальные и обезболивающие средства. Продолжительность курса терапии составляет от 3 до 6 месяцев. В этот период женщина принимает препараты, содержащие синтетические аналоги половых гормонов, которые способствуют росту фолликулов, овуляции и нормальному функционированию желтого тела. В результате лечения восстанавливается менструальный цикл, и яичники начинают функционировать в привычном режиме.
Сразу после завершения терапии придатки временно начинают производить яйцеклетки с повышенной интенсивностью. Увеличение их активности наблюдается в течение 1-3 месяцев, и именно в этот период рекомендуется планировать зачатие. Обычно это происходит сразу после окончания курса лечения. В это время, при условии активной работы придатков, существует вероятность многоплодной беременности.
После хирургического вмешательства планирование зачатия разрешается только после полного заживления внутренних и наружных швов, а также восстановления функций яичников, что занимает около 4-6 месяцев. Придатки могут начать функционировать уже в первые месяцы после операции, однако беременность в этот период может привести к различным осложнениям из-за недостаточного заживления ран и нестабильного гормонального фона.
ЭКО
Беременность с использованием экстракорпорального оплодотворения (ЭКО) применяется в тех случаях, когда медикаментозные или хирургические методы лечения истощенных яичников не приносят результатов, а естественное зачатие невозможно. Процесс включает в себя искусственное оплодотворение яйцеклетки женщины в лабораторных условиях, после чего оплодотворенная яйцеклетка помещается в матку.
Возможность вынашивания собственного ребенка с помощью ЭКО существует при наличии овуляции или зрелых фолликулов. Если фолликулы недостаточно зрелые для оплодотворения, может быть использована донорская яйцеклетка. Беременность таким образом иногда возможна даже при полном истощении яичников, однако для ее успешного поддержания требуется медикаментозная терапия, которая включает прием гормональных препаратов.

Суррогатное материнство
Этот метод применяется довольно редко. Истощение яичников можно успешно лечить, что дает возможность забеременеть как естественным, так и искусственным способом. Услуги суррогатных матерей становятся актуальными в тех случаях, когда ЭКО невозможно.
Если у женщины есть собственные зрелые яйцеклетки, то существует шанс выносить ребенка с ее генами. В противном случае прибегают к донорским яйцеклеткам или яйцеклеткам самой суррогатной матери.
Суррогатное материнство является довольно затратной услугой, поэтому, если зачатие генетически родного ребенка невозможно, стоит рассмотреть вариант усыновления.
Как проходит беременность в случае удачного зачатия при СИЯ
При успешном имплантировании эмбриона в матку на фоне синдрома истощенных яичников женщине требуется тщательное наблюдение со стороны гинеколога. Это актуально как для естественной беременности, так и для случаев, когда зачатие произошло с помощью ЭКО. После первого визита к врачу в период беременности рекомендуется пройти следующие обследования:
- УЗИ яичников – для определения наличия желтого тела, его размеров и функциональности;
- УЗИ матки – для выявления возможного тонуса матки;
- анализы крови на гормоны – для оценки необходимости назначения медикаментов в период беременности.
Чаще всего при синдроме истощенных яичников женщинам прописывают препараты, содержащие прогестерон. Это необходимо для поддержания адекватного уровня прогестерона в организме, правильного развития плода и предотвращения выкидыша. Прием этих медикаментов продолжается до 16-20 недели беременности.
Весь период беременности у пациенток с синдромом истощенных яичников не отличается от беременности у здоровых женщин. Исключение составляют более частые обследования, которые необходимы для контроля гормонального фона.
Профилактика патологии с целью будущего планирования беременности
Предотвращение истощения яичников основывается на поддержании гормонального баланса и здоровья репродуктивной системы. Для этого следует придерживаться ряда рекомендаций:
- посещение гинеколога дважды в год с обязательным прохождением всех необходимых обследований;
- сбалансированное и разнообразное питание;
- прием гормональных препаратов, включая оральные контрацептивы, только по рекомендации врача;
- соблюдение правил интимной гигиены;
- использование барьерных методов контрацепции;
- избегание переохлаждений;
- незамедлительное обращение к врачу при появлении болей внизу живота, нарушениях менструального цикла и других симптомах.
Чем раньше будет выявлен синдром истощенных яичников, тем быстрее можно ожидать улучшения состояния. Поздняя диагностика данного заболевания может привести к преждевременному климаксу и затруднениям с наступлением беременности.
Здоровье яичников в значительной степени зависит от нормального функционирования эндокринной системы. Ее нарушения могут спровоцировать истощение яичников. Лечение этого состояния обычно включает медикаментозную терапию, в редких случаях требуется хирургическое вмешательство. Если естественная беременность невозможна, может быть рекомендовано экстракорпоральное оплодотворение.

Психологические аспекты и поддержка при синдроме истощённых яичников
Синдром истощённых яичников (СИЯ) — это состояние, при котором яичники прекращают функционировать до 40 лет, что может привести к бесплодию и другим гормональным нарушениям. Однако, помимо физических аспектов, синдром также оказывает значительное влияние на психологическое состояние женщин, что требует особого внимания и поддержки.
Женщины, столкнувшиеся с СИЯ, часто испытывают широкий спектр эмоций, включая горе, тревогу, депрессию и чувство утраты. Эти чувства могут быть связаны с потерей возможности естественного зачатия, что является важной частью жизни для многих женщин. Психологические последствия могут усугубляться социальным давлением и ожиданиями, связанными с материнством, что делает поддержку особенно важной.
Психологическая поддержка может принимать различные формы. Индивидуальная терапия позволяет женщинам проработать свои чувства и научиться справляться с эмоциональными трудностями. Группы поддержки, где женщины могут делиться своим опытом и находить понимание среди тех, кто сталкивается с аналогичными проблемами, также могут быть очень полезными. В таких группах участницы могут обмениваться информацией о методах лечения, обсуждать свои переживания и находить поддержку в трудные времена.
Кроме того, важно учитывать, что женщины с СИЯ могут испытывать сложности в отношениях с партнёрами. Открытое и честное общение о чувствах и страхах может помочь укрепить связь и снизить уровень стресса. Пары могут рассмотреть возможность совместного посещения терапевта, чтобы работать над проблемами, возникающими в отношениях из-за диагноза.
Также стоит отметить, что некоторые женщины могут рассматривать альтернативные варианты материнства, такие как донорство яйцеклеток или усыновление. Эти варианты могут стать источником надежды и нового смысла, позволяя женщинам увидеть возможность стать матерью, даже если естественное зачатие невозможно.
В заключение, синдром истощённых яичников — это не только медицинская проблема, но и серьёзный психологический вызов. Поддержка со стороны специалистов, семьи и друзей играет ключевую роль в помощи женщинам справляться с эмоциональными последствиями этого состояния. Важно помнить, что каждая женщина уникальна, и подход к её поддержке должен быть индивидуальным, учитывающим её личные переживания и потребности.
Вопрос-ответ
Каковы основные причины синдрома истощённых яичников?
Синдром истощённых яичников может быть вызван различными факторами, включая генетические нарушения, аутоиммунные заболевания, инфекции, а также воздействие токсинов и некоторых медицинских процедур, таких как химиотерапия. В некоторых случаях причина остается неизвестной.
Каковы шансы на беременность при синдроме истощённых яичников?
Шансы на беременность при синдроме истощённых яичников зависят от степени истощения яичников и индивидуальных особенностей женщины. В некоторых случаях возможно естественное зачатие, но чаще всего требуется помощь репродуктивных технологий, таких как экстракорпоральное оплодотворение (ЭКО).
Какие методы лечения могут помочь при синдроме истощённых яичников?
Лечение синдрома истощённых яичников может включать гормональную терапию для регулирования менструального цикла и улучшения шансов на беременность. Также могут быть рекомендованы методы вспомогательной репродукции, такие как ЭКО с использованием донорских яйцеклеток, если собственные яйцеклетки не подходят для оплодотворения.
Советы
СОВЕТ №1
Обратитесь к врачу-репродуктологу для получения индивидуальной консультации. Специалист сможет оценить ваше состояние и предложить подходящие методы лечения или вспомогательные репродуктивные технологии.
СОВЕТ №2
Изучите возможности донорства яйцеклеток. Это может быть одним из вариантов для женщин с синдромом истощённых яичников, позволяющим достичь беременности с использованием донорских яйцеклеток.
СОВЕТ №3
Поддерживайте здоровый образ жизни. Правильное питание, регулярные физические нагрузки и отказ от вредных привычек могут положительно сказаться на общем состоянии здоровья и репродуктивной функции.
СОВЕТ №4
Не забывайте о психологическом аспекте. Поддержка со стороны близких и, при необходимости, консультации с психологом помогут справиться с эмоциональными трудностями, связанными с проблемами фертильности.